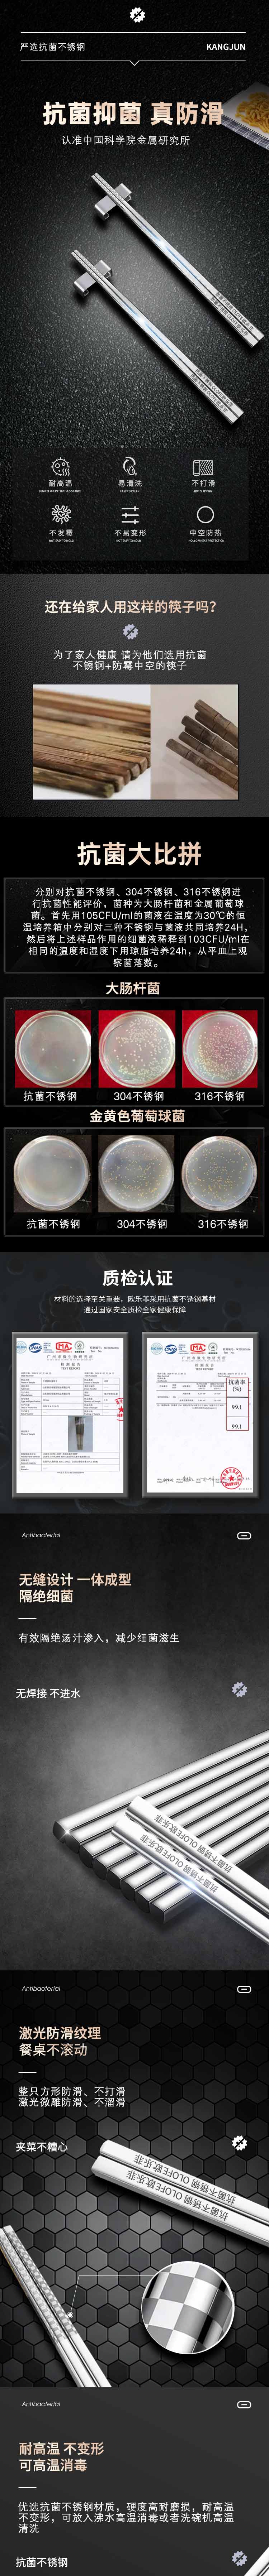

【官方正品保证】 欧乐菲抗菌不锈钢筷子高档防烫防霉家用家庭套装餐厅快子5双金属-OLOKZ-02
¥49.00
| 运费: | 免运费 |
| 库存: | 0 件 |
商品详情

- 码帮良品官方旗舰店 (微信公众号认证)
- 用做新闻的态度,寻找好产品——齐鲁晚报官方媒体新零售平台!
- 扫描二维码,访问我们的微信店铺
- 随时随地的购物、客服咨询、查询订单和物流...